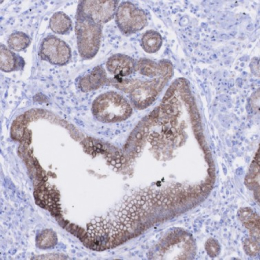

Price | 1784€+ Login to see price |
Organism | |
Product Type | |
Tissue | |
Disease | Gastric Cancer |
Drug Test (Organoid Only)
Establishing a process for isolating cytotoxic T cells that can directly attack cancer cells, creating an MHC-TCR
interaction environment, and utilizing MHC I/II blockers to achieve an immune microenvironment in vivo.
Using Immune Cell Co-culture
Establishing a process for isolating cytotoxic T cells that can directly attack cancer cells, creating an MHC-TCR
interaction environment, and utilizing MHC I/II blockers to achieve an immune microenvironment in vivo.
Using Cancer Associate Fibroblast
Establishing a process for isolating cytotoxic T cells that can directly attack cancer cells, creating an MHC-TCR
interaction environment, and utilizing MHC I/II blockers to achieve an immune microenvironment in vivo.

“...However, predicting drug responsiveness has been challenging due to variability between patients. Lambda Biologics’ patient-derived organoids address this issue by reflecting the unique characteristics of individual patients. These organoids allow...

“...However, predicting drug responsiveness has been challenging due to variability between patients. Lambda Biologics’ patient-derived organoids address this issue by reflecting the unique characteristics of individual patients. These organoids allow...

“...However, predicting drug responsiveness has been challenging due to variability between patients. Lambda Biologics’ patient-derived organoids address this issue by reflecting the unique characteristics of individual patients. These organoids allow...
Delve into the complexities of gastric cancer with our human gastric cancer(hGC) Organoids, engineered through pioneering 3D culture techniques to mirror the intricate ecosystem of human stomach tissues.
These models excel in reflecting the diverse cellular landscape, offering researchers a profound platform for groundbreaking studies and the development of targeted therapies.


Gastric cancer organoid
Our hGC Organoids are a breakthrough in gastric cancer research, meticulously engineered to replicate the specific tumor environment with the expression of key markers CK7, CEA, and LGR5.
This precise molecular reproduction not only ensures high fidelity in modeling but also deepens our understanding of gastric cancer pathology.
By mirroring the complex biology of patient tumors, our organoids facilitate the development of personalized therapies, opening new avenues for innovative treatment solutions.
Explore the possibilities with our hGC Organoids and lead the way in targeted cancer therapy.
H&E | CK7 | CEA | LGR5 | |
|---|---|---|---|---|
Cancer tissue |  | |  |  |
Cancer organoid |  |  |  |  |
Unlock the essence of precision in cancer treatment with our GC organoids, mirroring the genetic markers of gastric cancer.
Experience the future of testing you drugs, serving as an invaluable tool in capturing the patient-specific characteristics, thereby providing a more accurate platform for studying tumor biology and testing Dive into a new era of oncology, where your individuality guides our innovation.

Performing WES analysis on 16 gastric cancer (hGC) samples, the top 30 gene mutations were observed to be noticeably present across the samples, indicating a high level of mutation.
According to these results, it appears that conducting experiments using the various types of gastric cancer samples we possess will likely yield results similar to those observed in actual human cases.
